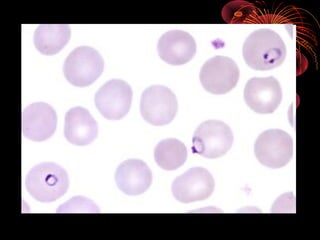
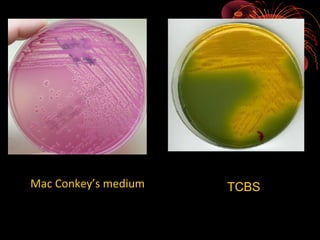
Mac Conkey’s medium

TCBS
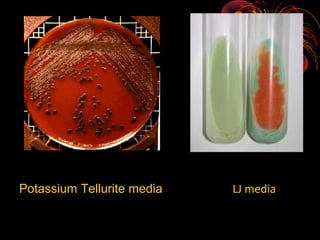
Potassium Tellurite media

LJ media

The document covers various aspects of microbiology, including key figures like Antony van Leeuwenhoek and Edward Jenner, who contributed to the field through their discoveries in microscopy and vaccination. It discusses classifications of microorganisms, laboratory techniques, and the growth and reproduction of bacteria. Important topics include different types of culture media and their uses, as well as measurements and characteristics of bacteria.